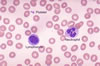

| Notrofil |
Notrofil |

Notrofil |

Notrofil |
| Akyuvar hücresi.Nötrofil granülosit olarak da adlarılan lökosit (akyuvar) hücresi. Sahip olduğu granüller, boyalara özel bir afinite (bağlanma eğilimi) göstermediği için "nötrofil" olarak adlandırılmıştır. |